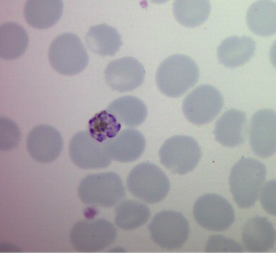
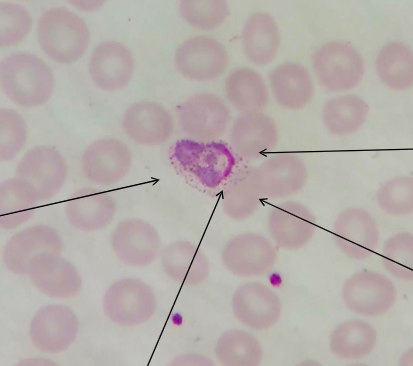
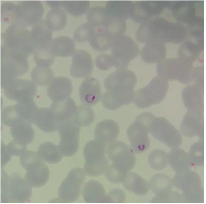
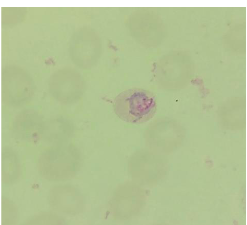
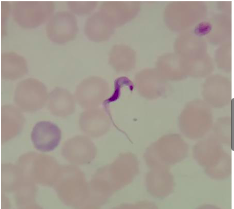

4F in West Africa presents with lethargy, fever, hepatosplenomegaly. What does the blood film show?
Later/mature stage schizont of suspected Plasmodium species
8-11 merozoites arranged peripherally within a microcytic RBC.
Haemozoin pigment (green/yellow content) is visible centrally within the
RBC as - a “daisy head” form
Plasmodium Malariae
What is the specimen on stool microscopy?

Schistosoma mansoni
Schistosoma mansoni egg measuring ~150 long by 55 μm wide.
Light yellow/brown, elongated oval shape and with a characteristic prominent lateral spine near the posterior end.
Contains a miracidium.
Describe the specimen
Thin blood film
Enlarged irregular parasitised RBC
Irregular Cytoplasm with large nucleus
Amoeboid trophozoite
Schuffner’s dots
10F with respiratory symptoms, pyrexia and R knee swelling. Her blood culture is attached. What is the description and likely diagnosis?

Gram +ve cocci in clusters
Likely to be Staph Aureus (must check for MR status)
You have a 40F patient from Brazil who presents with Hear Block.
What does the tissue biopsy show?

Tissue Biopsy
Oval amastigote in keeping with Chagas Disease
Child with joint swelling and cough.
What might this be?

Staph Aureus
Gram positive Cocci in clumps
A 28 year old male patient presented to the School’s Clinic with a history of fever and rigors occurring every 48 hours for the past 6 days. Each bout of fever lasted 4 hours.
He had returned from Kenya 3 months previously.
The week before his return he was treated in Nairobi for Plasmodium falciparum malaria with Fansidar.
On examination in the clinic he looked well and had a temperature of 36.4ºC.
Thick and thin blood films were taken.
Describe this film

Thick film:
parasites2:1 hpf,
Younger trophozoites, some rings.
Older, larger trophs with ‘halo’ of schuffners dots. These parasites fairly compact
A 28 year old male patient presented to the School’s Clinic with a history of fever and rigors occurring every 48 hours for the past 6 days. Each bout of fever lasted 4 hours.
He had returned from Kenya 3 months previously.
The week before his return he was treated in Nairobi for Plasmodium falciparum malaria with Fansidar.
On examination in the clinic he looked well and had a temperature of 36.4ºC.
Thick and thin blood films were taken.
Describe this film

Occasional gametocytes, solid and
rounded, again, compact
parasites.
Early and developing, immature schizonts.
Some mature schizonts
with 8-12 merozoites.
A 28 year old male patient presented to the School’s Clinic with a history of fever and rigors occurring every 48 hours for the past 6 days. Each bout of fever lasted 4 hours.
He had returned from Kenya 3 months previously.
The week before his return he was treated in Nairobi for Plasmodium falciparum malaria with Fansidar.
On examination in the clinic he looked well and had a temperature of 36.4ºC.
Thick and thin blood films were taken.
Describe this film
Thin film: parasites fairly
scanty in thin.
Some younger trophozoites, some rings, in only slightly enlarged RBCs
Blood film, returning traveller
Later trophozoites with more cytoplasm and more obvious Schuffners dots.
Generally compact parasites in only
slightly enlarged red cells, some parasitised cells showing fimbriation
Blood film, returning traveller

Oval or rounded solid looking gametocytes, with pigment and Schuffners dots.
A medical entomologist from the UK spent 1 month on a mosquito-hunting trip in Uganda.
Whilst in Uganda he had been treated for P. falciparum.
Two days after his return to LSTM Liverpool he suffered headache, a feeling of chill, nausea and mild diarrhoea; he consulted his doctor. A sample of his blood was observed by microscopy
Short stumpy forms (injected by tsetse fly) during blood feed
Long, slender trypomastigotes, dividing forms
Note: undulating membrane, central nucleus. Small terminal kinetoplast
How big is this?

55-65um
What is the size of this?

60-70 um
- Diphyllobothrium Latum
- Ova
- Pale yellow brown
- Oval
- 60-70um
- Operculum can be seen at one end
- Granulated yolk cells around an undeveloped ovum
- Within the ova there is a mass of granulated yolk cells


